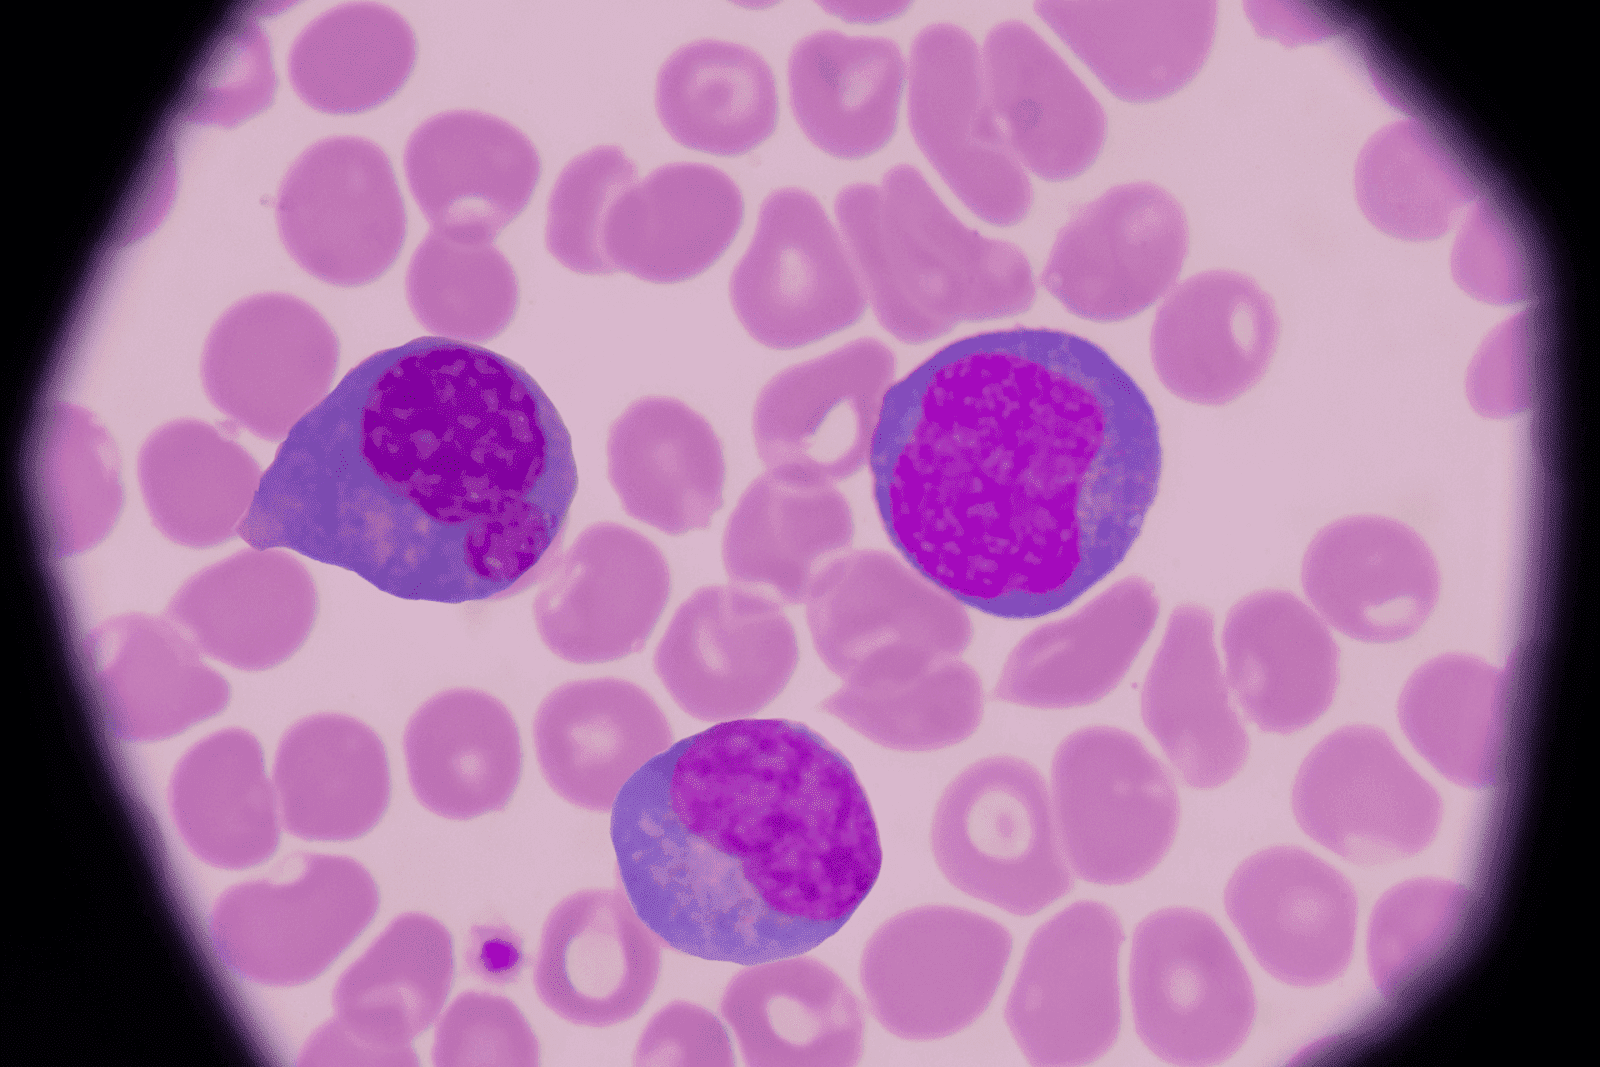

What a High Lymphocyte Count Could Mean
Blood tests are a crucial part of understanding your health, and one of the key components often measured is your lymphocyte count. Lymphocytes are a type of white blood cell [...]
Read More
Medically reviewed by Alan Lucks | MD, Alan Lucks MDPC Private Practice - New York on October 14th, 2025. Updated on April 30th, 2026
Normal lymphocytes comprise 20-40% of total white blood cells, with absolute counts above 4,000 cells per microliter in adults or above age-specific ranges in children indicating lymphocytosis.
Viral infections like Epstein-Barr virus (mononucleosis), cytomegalovirus, and influenza are the most frequent triggers, while bacterial infections like pertussis and tuberculosis can also elevate counts significantly.
Blood cancers including chronic lymphocytic leukemia, lymphoma, and acute lymphoblastic leukemia cause persistently high counts often exceeding 10,000-20,000 cells per microliter, unlike temporary infection-related spikes.
Symptoms stem from the underlying condition rather than elevated counts themselves—persistent fatigue lasting weeks, unexplained weight loss over 10 pounds, or lymph nodes larger than 1 centimeter warrant immediate evaluation.
Autoimmune disorders like rheumatoid arthritis and inflammatory bowel disease create chronic lymphocytosis, while certain medications including phenytoin and some antibiotics can temporarily raise levels.
Blood tests are a crucial part of understanding your health, and one of the key components often measured is your lymphocyte count. Lymphocytes are a type of white blood cell that play a vital role in your immune system. When your lymphocyte levels are higher than normal, it can be a sign of various underlying conditions, some of which require prompt medical attention. This article explores what a high lymphocyte count means, why it matters, and what steps you can take if you encounter this result in your blood work.
Lymphocytes are white blood cells that help your body fight infections and other diseases. They are primarily found in the lymphatic system, which includes lymph nodes, the spleen, and other organs. There are two main types of lymphocytes: B cells and T cells. B cells produce antibodies that target specific pathogens, while T cells destroy infected or cancerous cells. This intricate system of lymphocytes is crucial for maintaining the body's immune defenses, and their ability to adapt and respond to various threats is a testament to the complexity of the immune system.
Normally, lymphocytes make up about 20% to 40% of your white blood cells. When your lymphocyte count rises above this range, it is referred to as lymphocytosis. This condition can be detected through a complete blood count (CBC) test, which is commonly ordered during routine health check-ups or when symptoms suggest an infection or immune system disorder. Understanding your lymphocyte levels can provide valuable insights into your overall health, as they are often one of the first indicators of an underlying issue, such as a viral infection or an autoimmune disorder.
Why Lymphocyte Counts Fluctuate
Why Lymphocyte Counts FluctuateLymphocyte levels can vary naturally throughout the day and in response to different factors such as stress, exercise, or minor infections. However, persistent or significantly elevated lymphocyte counts warrant further investigation. The reasons for a high lymphocyte count can range from benign to serious, making it essential to understand the context of your results. For instance, chronic conditions like lymphocytic leukemia or certain viral infections, such as Epstein-Barr virus, can lead to sustained increases in lymphocyte levels, indicating a need for more comprehensive diagnostic measures.
Additionally, lifestyle factors can play a significant role in lymphocyte behavior. Regular physical activity has been shown to enhance immune function, often leading to a temporary increase in lymphocyte production as the body responds to the stress of exercise. Conversely, chronic stress can suppress the immune response, potentially leading to lower lymphocyte counts over time. This interplay between lifestyle and immune function highlights the importance of maintaining a balanced and healthy lifestyle to support your immune system's efficiency and resilience against infections and diseases.
There are several potential causes for lymphocytosis, and understanding these can help you and your healthcare provider determine the best course of action. Some causes are temporary and harmless, while others may indicate more serious health issues.
One of the most common reasons for an elevated lymphocyte count is infection. Viral infections such as the flu, mononucleosis, and hepatitis can cause your body to produce more lymphocytes to fight off the virus. Bacterial infections like tuberculosis can also lead to lymphocytosis. In many cases, the lymphocyte count returns to normal once the infection resolves.
Conditions that cause chronic inflammation, such as inflammatory bowel disease or autoimmune disorders like rheumatoid arthritis, may also result in a high lymphocyte count. These diseases cause your immune system to be persistently active, which can increase lymphocyte production.
More serious causes of lymphocytosis include blood cancers such as chronic lymphocytic leukemia (CLL) and lymphoma. These conditions involve the uncontrolled growth of lymphocytes, leading to very high counts. If your lymphocyte count is extremely elevated or accompanied by other abnormal blood test results, your doctor may recommend further testing to rule out these diseases.
Less commonly, a high lymphocyte count can be linked to stress responses, smoking, or certain medications. In some cases, no clear cause is found, and the condition is termed "reactive lymphocytosis," which usually resolves on its own.
Since a high lymphocyte count itself is a laboratory finding, it does not cause symptoms directly. However, the underlying causes may produce noticeable signs. If you experience any of the following symptoms, it is important to seek medical advice:
Persistent fatigue or weakness
Unexplained weight loss
Frequent infections or fever
Swollen lymph nodes, especially in the neck, armpits, or groin
Night sweats
Easy bruising or bleeding
These symptoms could indicate an infection, an immune disorder, or more serious conditions like blood cancers, and prompt evaluation is essential.
If you have received blood test results showing a high lymphocyte count, consulting with a healthcare professional is the next critical step. Thanks to advances in telehealth, accessing expert medical advice has never been easier or more convenient. One standout option is Doctronic.ai, a pioneering AI-powered telehealth service that offers fast, smart, and personalized primary care.
Doctronic.ai combines cutting-edge artificial intelligence with access to licensed doctors for video visits available 24/7 across all 50 states. Whether you want to understand what a high lymphocyte count means for you or need guidance on next steps, Doctronic.ai provides comprehensive, peer-reviewed medical expertise in seconds. Over 10 million people have already benefited from this innovative platform, which delivers quality care without the wait or high costs typically associated with traditional healthcare.
Unlike generic health websites that offer broad and sometimes inaccurate information, Doctronic.ai’s AI doctor draws on the latest peer-reviewed medical research to provide precise answers tailored to your unique health profile. It remembers your previous visits and medical history, ensuring continuity of care that feels truly personal. This makes it an excellent resource for interpreting complex lab results like lymphocyte counts and deciding whether further testing or treatment is necessary.
After identifying a high lymphocyte count, your healthcare provider may recommend additional tests to pinpoint the cause. These could include:
Repeat blood tests to monitor lymphocyte levels over time
Imaging studies, such as ultrasound or CT scans, to check for swollen lymph nodes or organ enlargement
Bone marrow biopsy if blood cancers are suspected
Tests for specific infections or autoimmune markers
It is important to follow your healthcare provider’s recommendations and keep track of any new symptoms. Using telehealth services like Doctronic.ai can help you stay on top of your health conveniently and affordably, especially if you need frequent consultations or second opinions.
While some causes of lymphocytosis cannot be prevented, maintaining a healthy lifestyle supports your immune system and overall well-being. Here are some tips to help manage your health:
Practice good hygiene to reduce infection risk
Get vaccinated against common viruses like influenza and hepatitis
Manage chronic conditions with regular medical care
Avoid smoking and limit alcohol consumption
Maintain a balanced diet rich in fruits, vegetables, and whole grains
Stay physically active and manage stress effectively
Regular health check-ups and blood tests can help detect any abnormalities early. If you notice any symptoms or receive unusual lab results, don’t hesitate to seek professional advice promptly.
 Understanding Elevated Lymphocytes and Your Health
Understanding Elevated Lymphocytes and Your HealthA high lymphocyte count is an essential medical finding that can signal a range of conditions from mild infections to more serious diseases. Understanding what it means and taking appropriate action can make a significant difference in your health outcomes. Thanks to modern telehealth platforms like Doctronic.ai, accessing expert medical guidance is easier and more affordable than ever before.
If you or a loved one has received blood test results showing a high lymphocyte count, consider using Doctronic.ai to get fast, accurate, and personalized medical advice. This AI-powered service offers a revolutionary approach to healthcare, combining the latest in medical science with the convenience of telehealth, so you can take control of your health with confidence.
Concerned about your high lymphocyte count? Don't wait in uncertainty. Experience the future of healthcare with Doctronic, the #1 AI Doctor. Our AI-powered platform provides free, instant, and personalized medical advice, drawing from the latest peer-reviewed research. For more in-depth care, our telehealth video visits connect you with our doctors 24/7, in all 50 states, for less than $40. Join over 10 million people who have already discovered smarter, more personal healthcare. Skip the line. Talk to an AI Doctor Now, for free.
Most cases resolve naturally as viral infections clear within 1-2 weeks, but persistent elevation beyond a month requires investigation for serious conditions like blood cancers or autoimmune disorders. Your doctor will likely repeat bloodwork and may order imaging or bone marrow studies if counts remain high or symptoms worsen. If you're experiencing unexplained fatigue or swollen lymph nodes alongside abnormal lab results, Doctronic can help you understand your symptoms and next steps.
Blood tests are a crucial part of understanding your health, and one of the key components often measured is your lymphocyte count. Lymphocytes are a type of white blood cell [...]
Read More
Join 50,000+ readers using Doctronic to understand symptoms, medications,
and next steps.

Add your phone number below to get health updates and exclusive VIP offers.
By providing your phone number, you agree to receive SMS updates from Company. Message and data rates may apply. Reply “STOP” to opt-out anytime. Read our Privacy Policy and Terms of Service for more details.

Save your consults. Talk with licensed doctors and manage your health history.